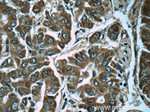
PGM1 Antibody in Immunohistochemistry (Paraffin) (IHC (P))
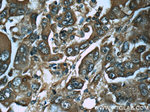
PGM1 Antibody in Immunohistochemistry (Paraffin) (IHC (P))

Search
Proteintech
PGM1 Monoclonal Antibody (2G5A8)
{{$productOrderCtrl.translations['antibody.pdp.commerceCard.promotion.promotions']}}
{{$productOrderCtrl.translations['antibody.pdp.commerceCard.promotion.viewpromo']}}
{{$productOrderCtrl.translations['antibody.pdp.commerceCard.promotion.promocode']}}: {{promo.promoCode}} {{promo.promoTitle}} {{promo.promoDescription}}. {{$productOrderCtrl.translations['antibody.pdp.commerceCard.promotion.learnmore']}}
产品信息
66105-1-IG
种属反应
宿主/亚型
分类
类型
克隆号
抗原
偶联物
形式
浓度
规格
纯化类型
保存液
内含物
保存条件
运输条件
产品详细信息
Immunogen sequence: SGPNRLKIC IDAMHGVVGP YVKKILCEEL GAPANSAVNC VPLEDFGGHH PDPNLTYAAD LVETMKSGEH DFGAAFDGDG DRNMILGKHG FFVNPSDSVA VIAANIFSIP YFQQTGVRGF ARSMPTSGAL DRVASATKIA LYETPTGWKF FGNLMDASKL SLCGEESFGT GSDHIREKDG LWAVLAWLSI LATRKQSVED ILKDHWQKHG RNFFTRYDYE EVEAEGANKM MKDLEALMFD RSFVGKQFSA NDKVYTVEKA DNFEYSDPVD GSISRNQGLR LIFTDGSRIV FRLSGTGSAG ATIRLYIDSY EKDVAKINQD PQVMLAPLIS IALKVSQLQE RTGRTAPTVI T (213-562 aa encoded by BC001756)
靶标信息
Phosphoglucomutases (PGM; EC 5.4.2.2) catalyze the transfer of phosphate between the 1 and 6 positions of glucose. Isozymes of PGM are monomeric, with molecular masses of about 60 kD, and are encoded by several genes, including PGM1. In most cell types, PGM1 isozymes predominate, representing about 90% of total PGM activity. One exception is red cells, where PGM2 (MIM 172000) is a major isozyme (Putt et al., 1993 [PubMed 8257433]). [supplied by OMIM].
仅用于科研。不用于诊断过程。未经明确授权不得转售。
篇参考文献 (0)
生物信息学
蛋白别名: ARABIDOPSIS THALIANA PHOSPHOGLUCOMUTASE; ATPGMP; Glucose phosphomutase 1; MIO24.4; MIO24_4; PGM; PGM 1; PGM1; PHOSPHOGLUCOMUTASE; Phosphoglucomutase-1; STARCH-FREE 1; STF1; unnamed protein product
基因别名: CDG1T; GSD14; PGM1
UniProt ID: (Human) P36871
Entrez Gene ID: (Human) 5236